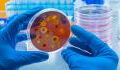
Ausbruch von seltenen Affenpocken beim Menschen: Das Virus kann zur kompletten Erblindung führen

Nach der Covid-19-Pandemie, die die Welt in eine große gesundheitliche und wirtschaftliche Krise gestürzt hat, erleben wir das Auftreten anderer beunruhigender Viren wie die Affenpocken oder nun die Afrikanische Schweinepest. Welche Risiken birgt das Vorhandensein eines solchen Virus in Europa mit sich?
Ausbruch der Schweinepest in Süddeutschland
Am Donnerstag, den 26. Mai, wurde laut Spiegel in einem Schweinezuchtbetrieb in Deutschland, nur wenige Kilometer von der französischen Grenze entfernt, in Forchheim am Kaiserstuhl, ein Ausbruch der Afrikanischen Schweinepest festgestellt.
"Bisher wurde kein Fall bei Wildtieren im umliegenden Gebiet festgestellt", erklärte das französische Landwirtschaftsministerium laut Libération in Bezug auf diesen Zuchtbetrieb, in dem sich insgesamt 35 Schweine befinden sollen.
Die Gesundheitsbehörden sind in Alarmbereitschaft, da für die nächste Woche ein Krisenstab angekündigt wurde, der laut Ministerium "alle Fachleute und staatlichen Stellen" einbeziehen soll.
Das Schweinepestvirus ist in Deutschland, aber auch in Italien präsent und zirkuliert somit in Europa, weniger als 100 Kilometer von den französischen Grenzen entfernt.
Dies beunruhigt die Gesundheitsbehörden in der Region. Ein Notfallplan zur Eindämmung des Virus rund um Rom war bereits in den Anfängen dieses Jahres 2022 gestartet worden.
Was ist das Virus und wie hoch sind die Risiken?
Das Virus mit dem Namen "Afrikanische Schweinepest" zirkuliert weltweit in 38 Ländern innerhalb von fünf Kontinenten. Es wird zwar nicht direkt auf den Menschen übertragen, kann aber nach Ansicht von Expert:innen aus der Landwirtschaft mit der Vogelgrippe vergleichbar sein.
Bisher gibt es keine Behandlungsmöglichkeiten für Tiere, die mit dem Virus infiziert sind: Wildschweine, Warzenschweine und Schweine sterben in der Regel an den Folgen der Krankheit.
Um eine weitere Ausbreitung zu verhindern, sind die Landwirt:innen angewiesen, bei Verdacht auf einen Seuchenausbruch den gesamten Seuchenherd zu töten.
Das Virus kann inbesondere für Tiere sehr gefährlich sein und zwei Monate lang im Fleisch überleben: Die Symptome bei einer Infektion sind sehr hohes Fieber, Appetitlosigkeit sowie Hautverletzungen. Das Bundesminiterium für Ernährung und Landwirtschaft fügt dennoch hinzu:
Für den Menschen stellt sie keine Gefahr dar; auch nicht beim etwaigen Verzehr von mit dem ASP-Virus kontaminiertem Schweinefleisch.
In Frankreich zeigt man sich trotzdem besorgt:
Seine Einschleppung nach Frankreich könnte schwerwiegende sozioökonomische und gesundheitliche Folgen für die betroffenen Berufszweige haben.
So lautet die Warnung des Landwirtschaftsministeriums daher zur Lage der französischen Viehzüchter:innen. Die Versorgung mit Lebensmitteln auf Schweinefleischbasis könnte in den nächsten Monaten gefährdet sein, so die zuständigen Behörden.
Aus dem Französischen übersetzt von Ohmymag Frankreich
Mehr Informationen:
⋙ Affenpocken: Bietet die klassische Pockenimpfung Schutz vor einer Ansteckung?
⋙ Awareness für Affenpocken: Deutsche Virologin erklärt, welche Gefahr von ihnen ausgeht
⋙ Affenpocken: WHO empfiehlt zur Eindämmung des Virus Covid-19-Maßnahmen